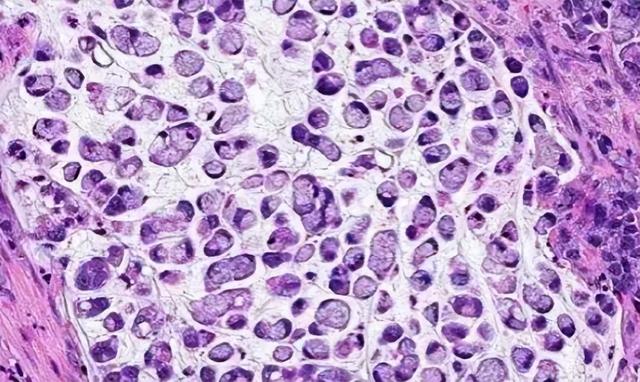
每天连吃三顿,39岁二孩爸爸确诊癌症晚期!这菜很多人都爱吃

文章图片

文章图片

文章图片

文章图片
文章图片
看着眼前这位年龄只有39岁的付先生 , 医生心中下定决心 , 一定要想办法救他 。
付先生是一个土生土长的农村人 , 家里有好几亩地 , 一直没出来打工 , 要他自己的话就是乡村田野间无比自由 , 出来受气干嘛?
在农村的付先生格外喜欢吃腌制食品 , 尤其是咸菜 , 当然这和他们整个村的习惯有关 , 几乎所有村民都养成了吃腌制食品的习惯 。
为了满足自己的喜好 , 付先生把田里种的青菜、萝卜一筐一筐的做成了腌制品 , 每天都吃一点 , 再配上小烟和小酒 , 过的简直是神仙日子 。
有时候吃咸菜上头了 , 付先生甚至会连着三餐都吃咸菜 , 十分下饭 。
但是随着年龄的增长 , 付先生不知从何时开始出现了吃完饭后胃部不适的症状 。 刚开始时 , 这种症状就还好 , 简单休息一下就恢复了 , 因此付先生只以为吃得太多难消化 , 并没有放在心上 。
可是 , 慢慢的这种症状就多了起来 , 而且越来越严重 , 去小镇的卫生医院做了检查 , 医生说可能是胃炎 , 开点抑制胃酸分泌的药吃吃就没事了 。
乡下人不懂太多的医学常识 , 付先生也只能听从医生的安排开始吃药 , 接下来一段时间 , 他总是会遭受腹痛 。 腹胀的侵扰 。 即使能熬过去 , 但有时候晚上痛起来还是难以支撑 。
更严重的事 , 他的食欲好像也越来越差 , 有时候只吃几口就完全没了胃口 , 稍微吃多一点就会出现彻夜疼痛的问题 。
无奈之下 , 付先生联系了城里的亲戚 , 他们推荐付先生到三甲医院做个全面检查 , 看看胃到底怎么样了 。
付先生和妻子坐了几个小时的车来到城里 , 随后直奔医院 。
来到医院后 , 医生了解了付先生的情况 , 立即推荐他做胃肠镜检查 , 付先生听都没听说过 , 问:“要多少钱”?
医生说:“一千多吧”!
付先生吓了一跳:“那么贵?医生开点药就算了” 。
医生说:“你的命重要还是钱重要”?
想来想去 , 付先生还是觉得自己的命比较重要 , 毕竟现在家里还有两个孩子以及两个老人要养 , 自己万一有什么问题 , 那就完蛋了 。
经过胃镜检查 , 医生发现付先生的胃中有一个直径5厘米的肿瘤 , 经过反复确认 , 最终付先生被确诊为晚期胃癌 , 同时有肝转移情况 。
付先生拿着检查报告在医院门口徘徊了很久很久 , 随后流下了眼泪 , 他找到肿瘤科的主任问道:“我还能活多久?早点来检查会不会好些?”
【每天连吃三顿,39岁二孩爸爸确诊癌症晚期!这菜很多人都爱吃】医生根据付先生的病情组织了MDT讨论 , 在会上多科室的带头人制定了转化、手术的治疗方针 。
经过4次化疗 , 付先生胃部的肿瘤明显缩小了一大半 , 肝部转移病灶消失 。 随后 , 外科医生团队给付先生做了胃癌切除手术 。
手术后 , 付先生还要做6个疗程的化疗 , 这样才算大功告成 。
复查 , 付先生的肿瘤病灶完全消失 , 恢复良好 , 出院回家后的他更忙碌地耕种家里的田地 , 种了一些和之前不同的蔬菜 。
- 建议每个女生每天坚持做这六个瑜伽体式
- 和尚每天都是吃素,为何还是肥头大耳?看看他们的“伙食”就懂了
- 每天4只,一男子确诊尿毒症!正大量上市,网友:根本停不下来……
- 天然的“止咳汤”找到了,每天煮一锅,止咳润肺,冬天少生病!
- 每天服用西地那非,是保护心血管,还是伤害身体?一文说清楚
- BMJ新研究:每天久坐6小时,女性子宫肌瘤风险翻倍!
- 每天早上吃个水煮蛋,是营养佳品还是血管祸根?吃鸡蛋别犯3个错
- 男子每天喝30斤水去50次厕所
- 连吃4种感冒药导致肾衰竭?医生紧急提醒→
- 72岁王石:运动狂人,每天跑步游泳健身,只为将来陪着女儿出嫁
